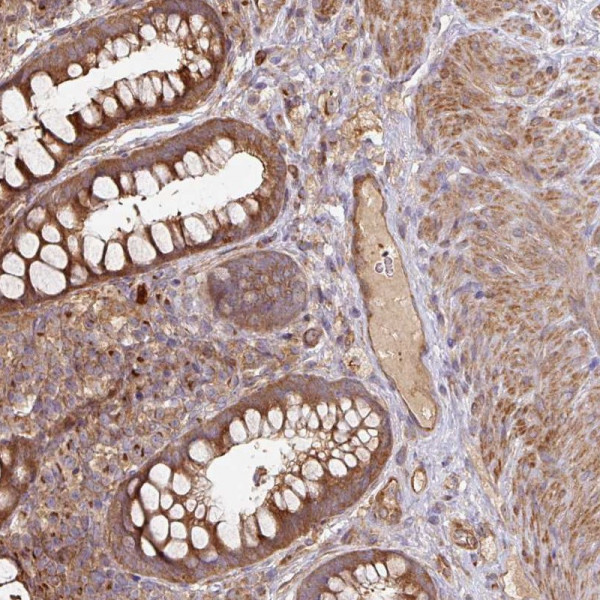
Anti-SIK1

Cookie preferences
This website uses cookies, which are necessary for the technical operation of the website and are always set. Other cookies, which increase the comfort when using this website, are used for direct advertising or to facilitate interaction with other websites and social networks, are only set with your consent.
Configuration
Technically required
These cookies are necessary for the basic functions of the shop.
"Allow all cookies" cookie
"Decline all cookies" cookie
CSRF token
Cookie preferences
Currency change
Customer-specific caching
FACT-Finder tracking
Individual prices
Selected shop
Session
Comfort functions
These cookies are used to make the shopping experience even more appealing, for example for the recognition of the visitor.
Note
Show the facebook fanpage in the right blod sidebar
Statistics & Tracking
Affiliate program
Conversion and usertracking via Google Tag Manager
Track device being used
| Item number | Size | Datasheet | Manual | SDS | Delivery time | Quantity | Price |
|---|---|---|---|---|---|---|---|
| ATA-HPA038211.25 | 25 µl | - |
7 - 10 business days* |
369.00€
|
|||
| ATA-HPA038211.100 | 100 µl | - |
7 - 10 business days* |
491.00€
|
If you have any questions, please use our Contact Form.
You can also order by e-mail: info@biomol.com
Larger quantity required? Request bulk
You can also order by e-mail: info@biomol.com
Larger quantity required? Request bulk
Protein function: Serine/threonine-protein kinase involved in various processes such as cell... more
Product information "Anti-SIK1"
Protein function: Serine/threonine-protein kinase involved in various processes such as cell cycle regulation, gluconeogenesis and lipogenesis regulation, muscle growth and differentiation and tumor suppression. Phosphorylates HDAC4, HDAC5, PPME1, SREBF1, CRTC1/TORC1. Inhibits CREB activity by phosphorylating and inhibiting activity of TORCs, the CREB- specific coactivators, like CRTC2/TORC2 and CRTC3/TORC3 in response to cAMP signaling (PubMed:29211348). Acts as a tumor suppressor and plays a key role in p53/TP53-dependent anoikis, a type of apoptosis triggered by cell detachment: required for phosphorylation of p53/TP53 in response to loss of adhesion and is able to suppress metastasis. Part of a sodium-sensing signaling network, probably by mediating phosphorylation of PPME1: following increases in intracellular sodium, SIK1 is activated by CaMK1 and phosphorylates PPME1 subunit of protein phosphatase 2A (PP2A), leading to dephosphorylation of sodium/potassium-transporting ATPase ATP1A1 and subsequent increase activity of ATP1A1. Acts as a regulator of muscle cells by phosphorylating and inhibiting class II histone deacetylases HDAC4 and HDAC5, leading to promote expression of MEF2 target genes in myocytes. Also required during cardiomyogenesis by regulating the exit of cardiomyoblasts from the cell cycle via down-regulation of CDKN1C/p57Kip2. Acts as a regulator of hepatic gluconeogenesis by phosphorylating and repressing the CREB-specific coactivators CRTC1/TORC1 and CRTC2/TORC2, leading to inhibit CREB activity. Also regulates hepatic lipogenesis by phosphorylating and inhibiting SREBF1. In concert with CRTC1/TORC1, regulates the light-induced entrainment of the circadian clock by attenuating PER1 induction, represses CREB- mediated transcription of PER1 by phosphorylating and deactivating CRTC1/TORC1. [The UniProt Consortium] Buffer: 40% glycerol and PBS (pH 7.2). 0.02% sodium azide is added as preservative. Highest antigen sequence identity to mouse: 71% and to rat: 71%
| Keywords: | Anti-SIK, Anti-SIK1, Anti-SIK-1, Anti-Salt-inducible kinase 1, Anti-Serine/threonine-protein kinase SIK1, Anti-Serine/threonine-protein kinase SNF1LK, Anti-Serine/threonine-protein kinase SNF1-like kinase 1 |
| Supplier: | Atlas Antibodies |
| Supplier-Nr: | HPA038211 |
Properties
| Application: | IHC |
| Antibody Type: | Polyclonal |
| Conjugate: | No |
| Host: | Rabbit |
| Species reactivity: | human |
| Immunogen: | Recombinant Protein Epitope Signature Tag (PrEST) antigen sequence: YLLLERLKEY RNAQCARPGP ARQPRPRSSD LSGLEVPQEG LSTDPFRPAL LCPQPQTLVQ SVLQAEMDCE LQSSLQWPLF FPVDASCSGV F (ATA-APrEST87281) |
Database Information
| KEGG ID : | K19008 | Matching products |
| UniProt ID : | P57059 | Matching products |
| Gene ID : | GeneID 102724428 | Matching products |
| Protein Atlas Nr. : | ENSG00000142178 |
Handling & Safety
| Storage: | -20°C |
| Shipping: | +20°C (International: +20°C) |
Caution
Our products are for laboratory research use only: Not for administration to humans!
Our products are for laboratory research use only: Not for administration to humans!
Information about the product reference will follow.
more
You will get a certificate here
Viewed

